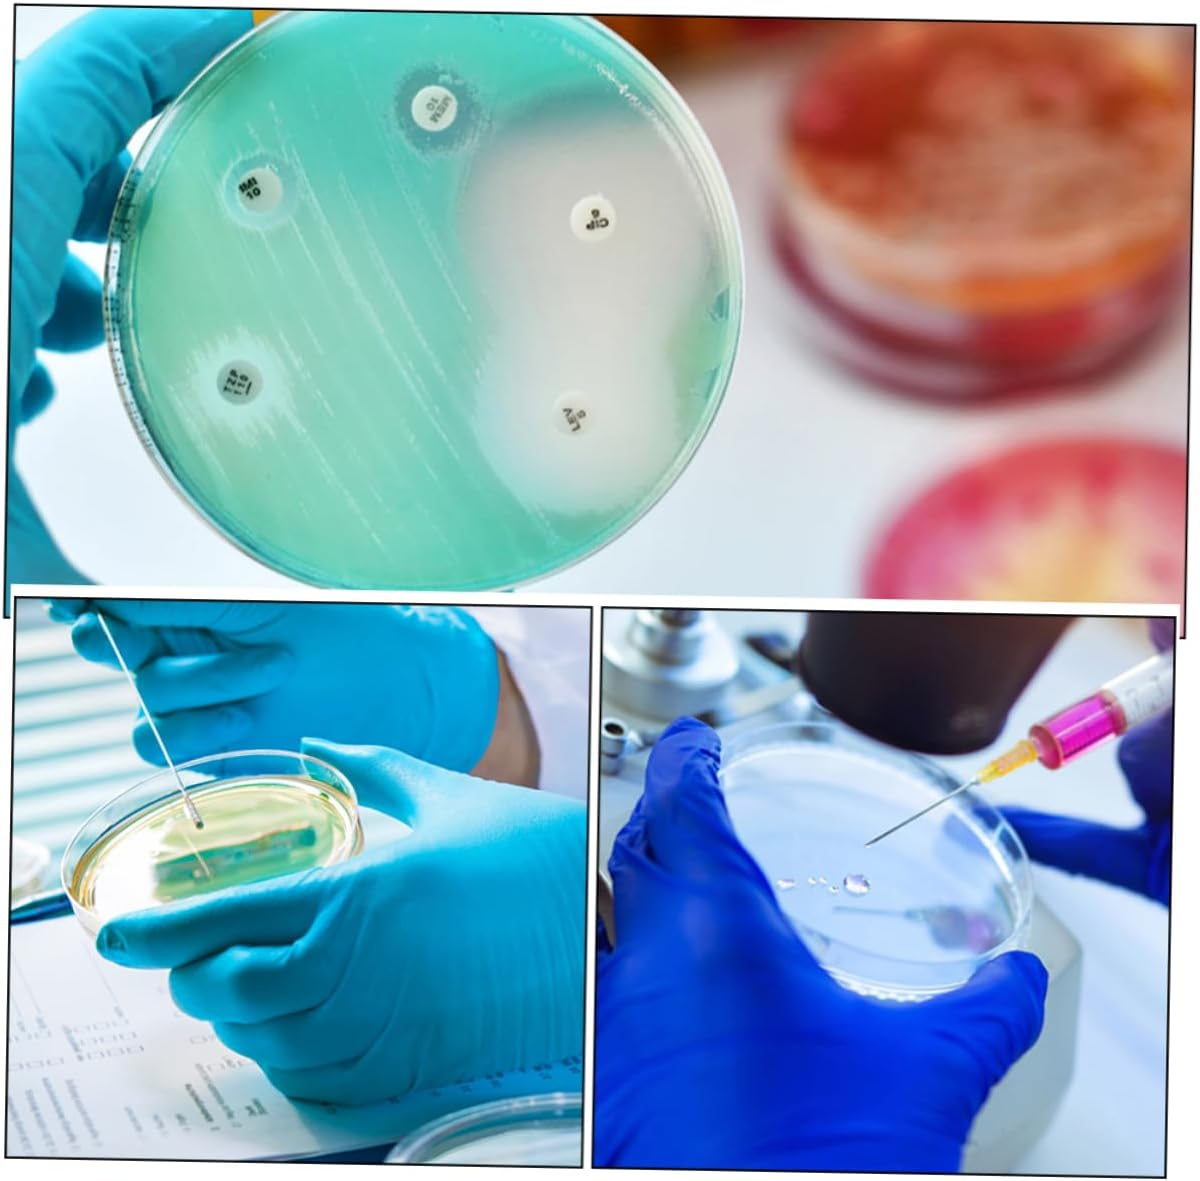
STOBOK 10 Pack Polycarbonate Autoclavable Lab Petri Dishes Culture Plates Agar Tissue Culture Dish for Science Experiments image number 1
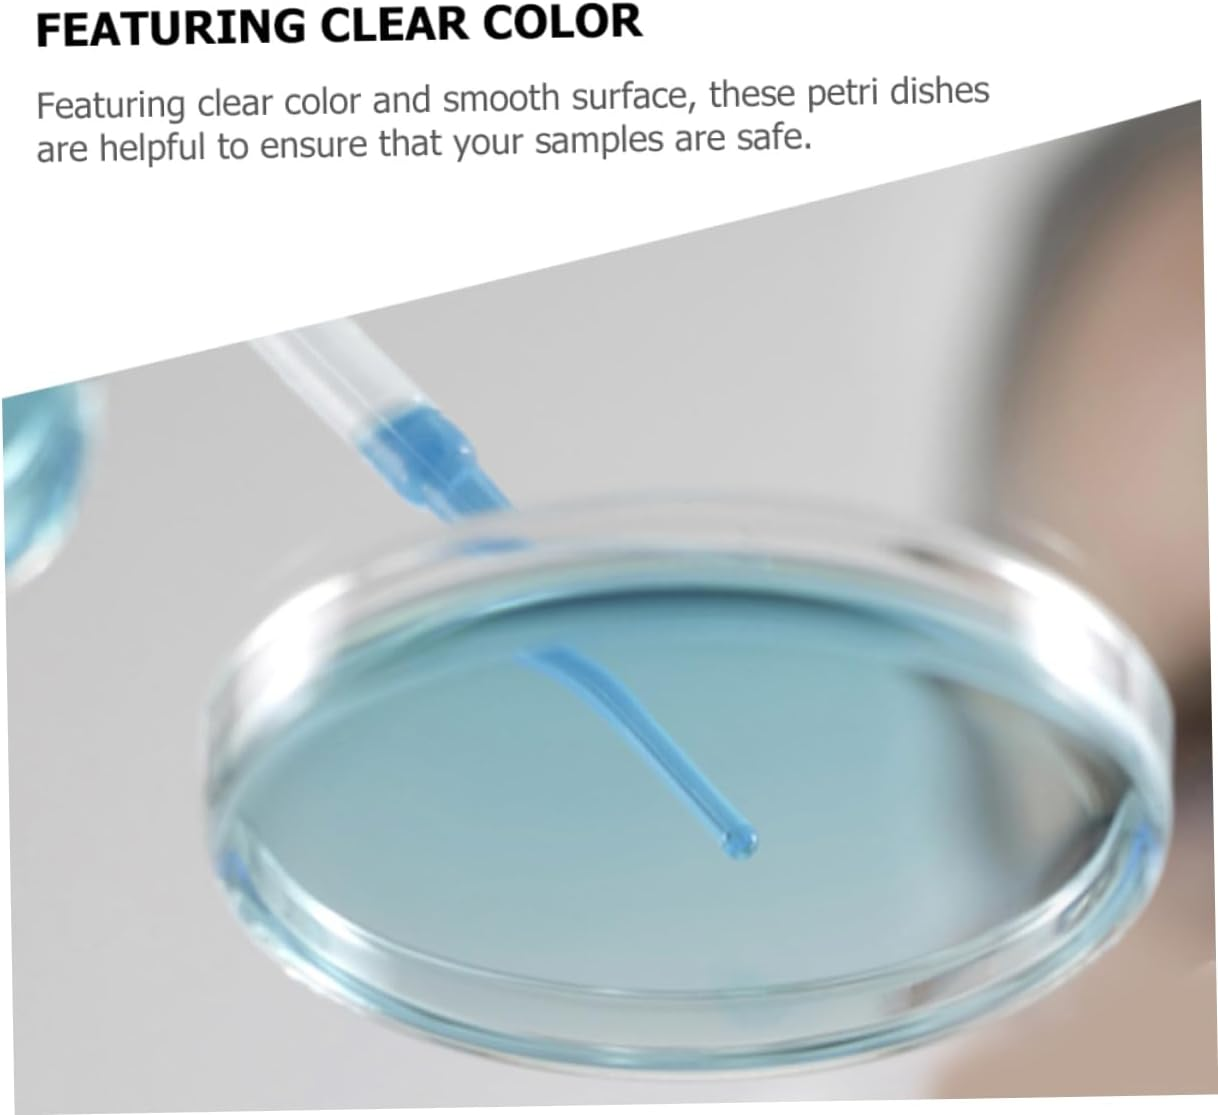
STOBOK 10 Pack Polycarbonate Autoclavable Lab Petri Dishes Culture Plates Agar Tissue Culture Dish for Science Experiments image number 6

STOBOK 10 Pack Polycarbonate Autoclavable Lab Petri Dishes Culture Plates Agar Tissue Culture Dish for Science Experiments


STOBOK 10 Pack Polycarbonate Autoclavable Lab Petri Dishes Culture Plates Agar Tissue Culture Dish for Science Experiments
- Petri dish: laboratory analysis for , biological, scientific research and other activities, suitable for general training.
- Petri dishes with lids: this culture plate are suitable for researchers to do experiments, wonderful for cell culture use.
- Clear culture plate: featuring clear color and smooth surface, these petri dishes are helpful to ensure that your samples are safe.
- Petri plates: suitable for any home, or laboratory use. enough quantity for you to use and replace.
- Petri dishes: adopted of plastic material, it is practical and durable for long time use, bring you much conveniences.
Package List
10 x Petri Dishes with Lids
Features
- Size: 5.50X5.50X1.50cm/2.16X2.16X0 science petri dishes.
-Material:Plastic culture plate
- Color: As Shown labs experiment device
-Multipurpose. Widely used for education, chemistry, research, or life science applications science petri dish.
-Suitable for any home, or laboratory use. Enough quantity for you to use and replace plastic petri plates.
-Adopted of plastic material, it is practical and durable for long time use, bring you much conveniences chemistry petri dish.
-Our petri dishes are suitable for students to do experiments and also scientific research lab dishes.
-Transparent color design, allows you to easily observe your samples and improve your efficiency reaction plate.
Goods Information
agar plates Professional chemistry experimental tools, these petri dishes make your experiment more successful. culture dish Small and lightweight, so that it can be carried with you anytime and anywhere.transparent cell culture plate Made of high-strength plastic material, this petri sturdy enough, and not easy to crack or break
- Colour: As Shown
- Manufacturer reference: 0JNH41GU9V402TJ38ECMHYSK
- Product dimensions: 5.5 x 5.5 x 1.5 cm; 0.06 Grams
- Manufacturer Part Number: 0JNH41GU9V402TJ38ECMHYSK
- Size: medium
- Brand: STOBOK
- Manufacturer: STOBOK
-
In Stock